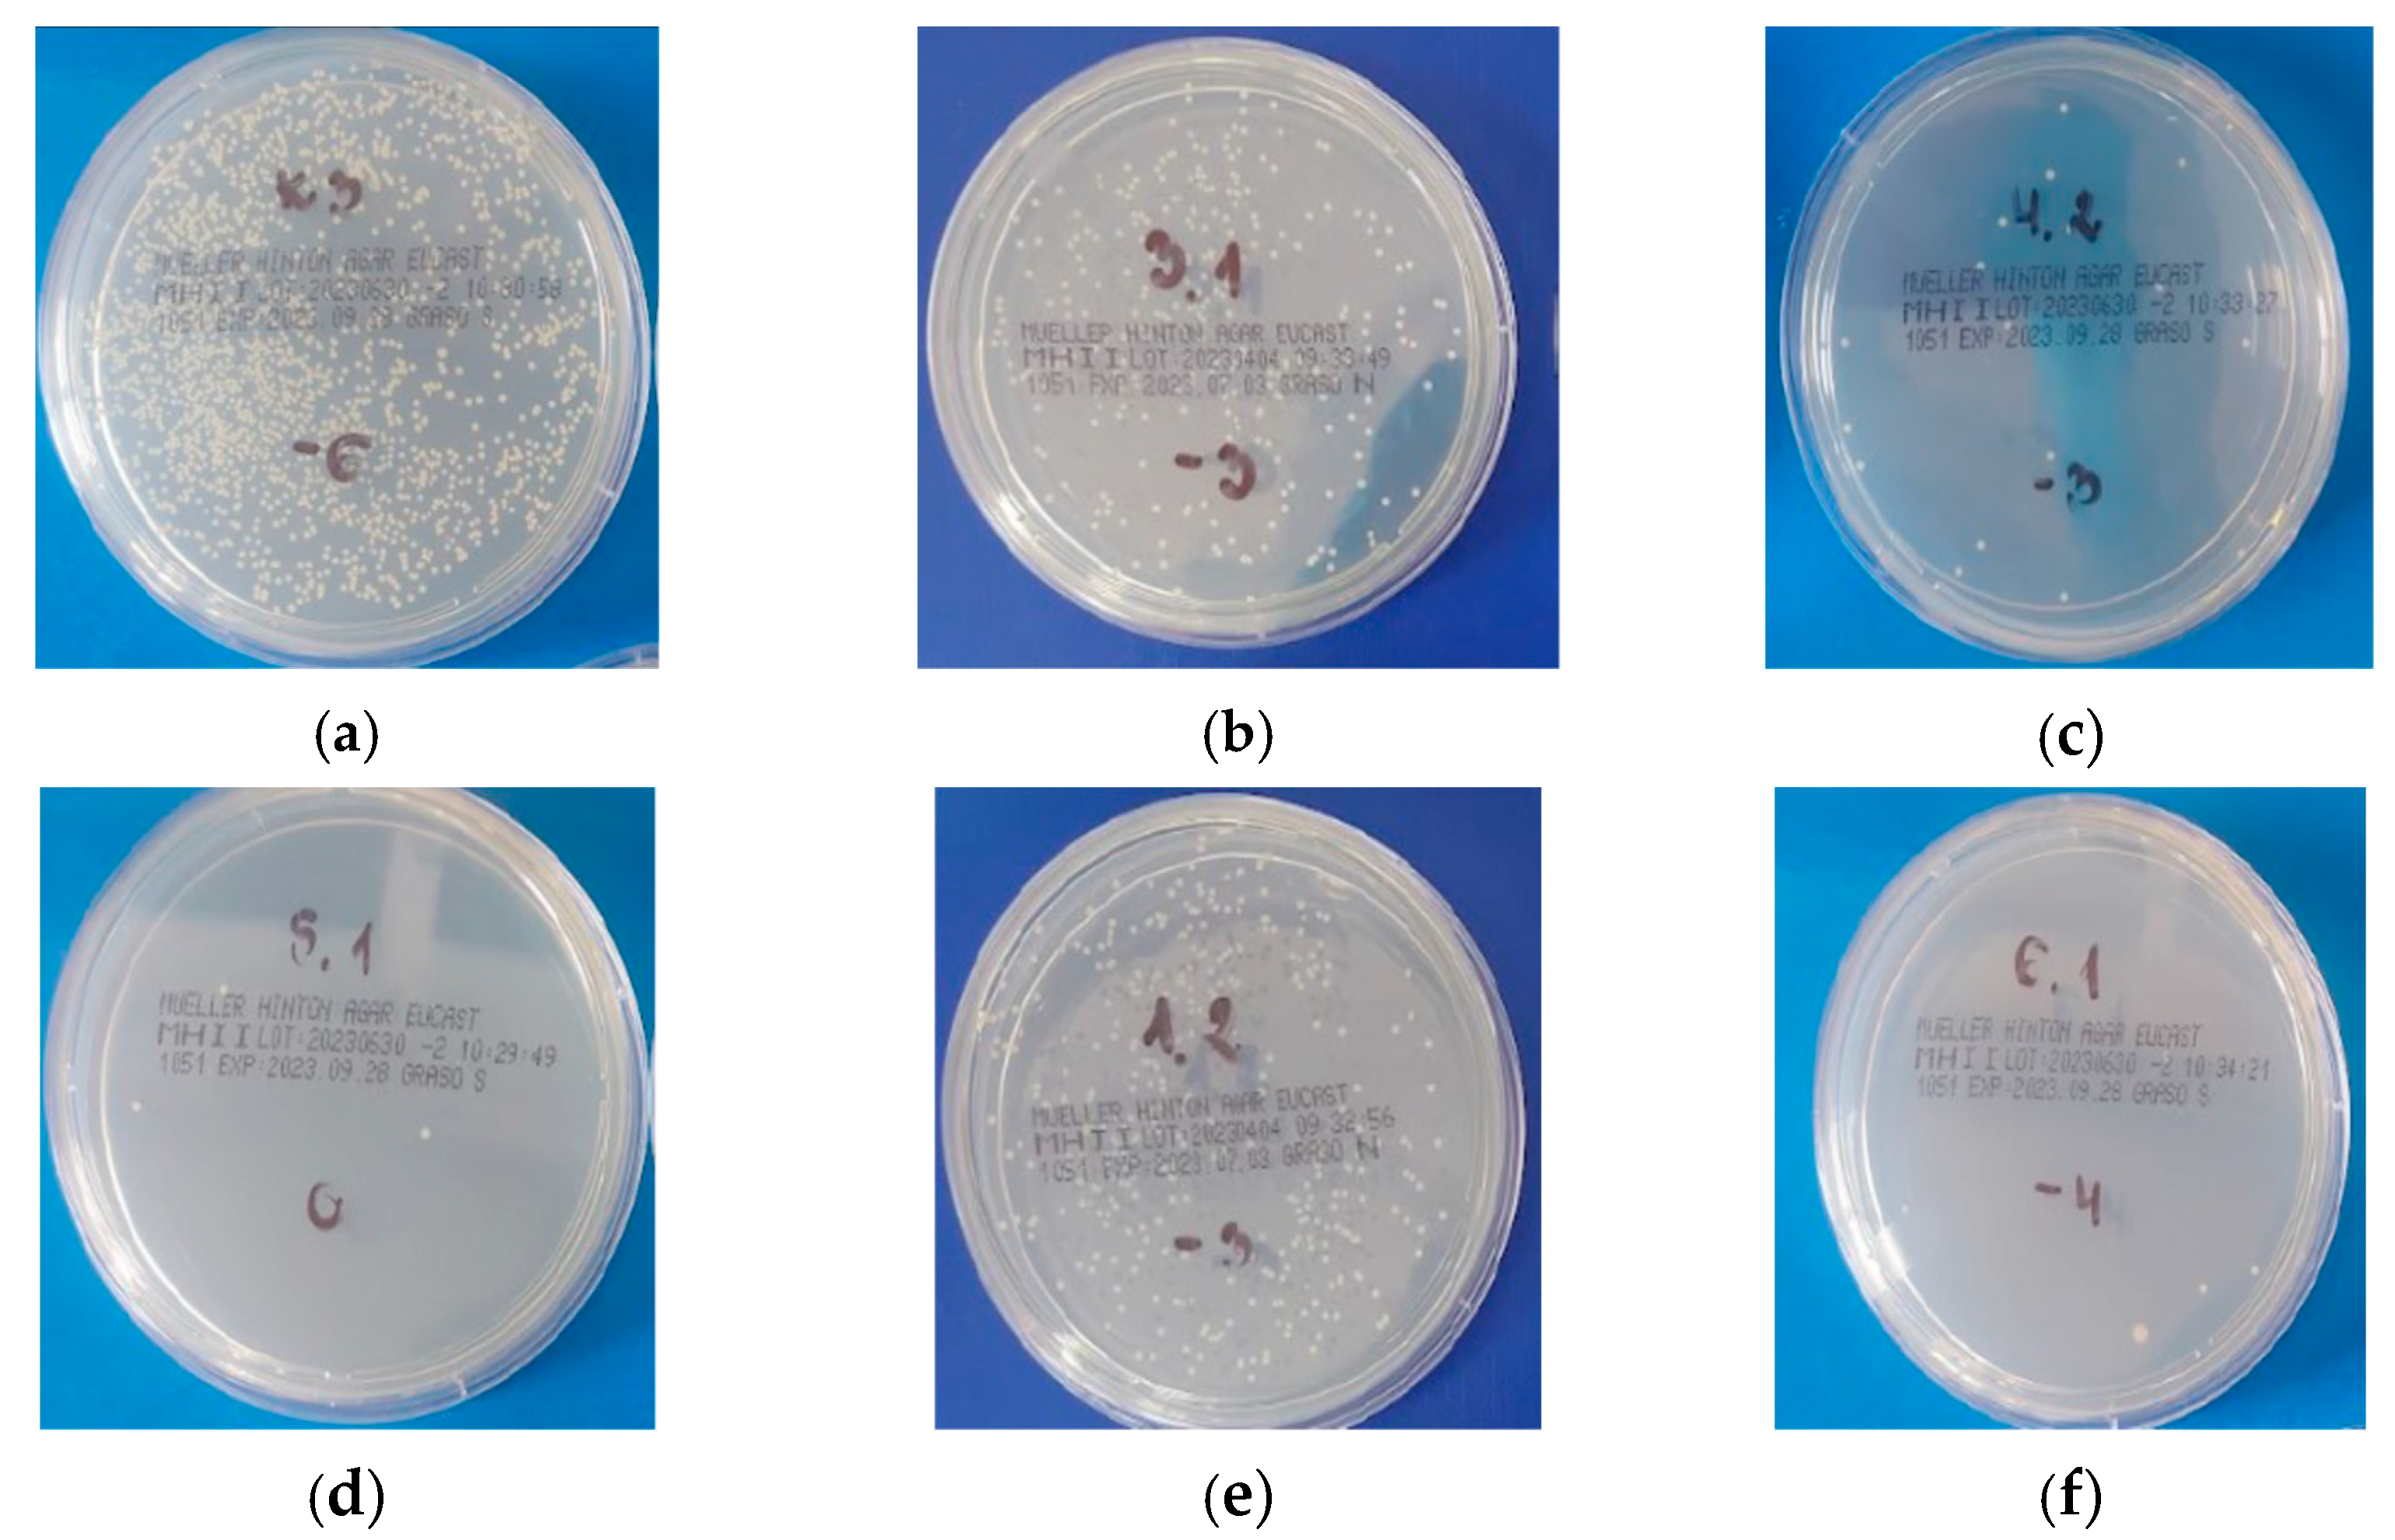
Blsf 35 00010 g003

Antibacterial Properties of Dental Copolymer Modified with Monomers Possessing Quaternary Ammonium Groups †
Abstract
:1. Introduction
2. Materials and Methods
2.1. Materials
2.2. Monomer Synthesis
2.3. Curing Procedure and Sample Preparation
2.4. Nuclear Magnetic Resonance Spectroscopy (NMR)
2.5. Bacterial Adhesion
3. Results
3.1. 1H and 13C Spectroscopy Analysis
3.2. Bacterial Adhesion
4. Discussion
5. Conclusions
Author Contributions
Funding
Institutional Review Board Statement
Informed Consent Statement
Data Availability Statement
Conflicts of Interest
References
- Lu, M.; Xuan, S.; Wang, Z. Oral microbiota: A new view of body health. Food Sci. Hum. Wellness 2019, 8, 8–15. [Google Scholar] [CrossRef]
- Rezaei, T.; Mehramouz, B.; Gholizadeh, P.; Yousefi, L.; Ganbarov, K.; Ghotaslou, R.; Taghizadeh, S.; Kafil, H.S. Factors Associated with Streptococcus mutans Pathogenicity in the Oral Cavity. Biointerface Res. App Chem. 2023, 13, 368–387. [Google Scholar]
- Eick, S.; Glockmann, E.; Brandl, B.; Pfister, W. Adherence of Streptococcus mutans to various restorative materials in a continuous flow system. J. Oral. Rehabil. 2004, 31, 278–285. [Google Scholar] [CrossRef] [PubMed]
- Badr, S.; Abdulrahman, A.; Abdullah, A.; Essam, A.; Mohammad, Y.; Shahzeb, H. Effect of various antibacterial materials in dental composites: A systematic review. Ann. Dent. Spec. 2021, 9, 39–44. [Google Scholar]
- Chen, L.; Suh, B.; Yang, J. Antibacterial dental restorative materials: A review. Am. J. Dent. 2018, 31, 6B–12B. [Google Scholar] [PubMed]
- Zhang, Y.; Chen, Y.; Hu, Y.; Huang, F.; Xiao, Y. Quaternary ammonium compounds in dental restorative materials. Dent. Mater. J. 2018, 37, 183–191. [Google Scholar] [CrossRef] [PubMed]
- Huang, L.; Xiao, Y.H.; Xing, X.D.; Li, F.; Ma, S.; Qi, L.L.; Chen, J.H. Antibacterial Activity and Cytotoxicity of Two Novel Cross-Linking Antibacterial Monomers on Oral Pathogens. Arch. Oral. Biol. 2011, 56, 367–373. [Google Scholar] [CrossRef] [PubMed]
- Liang, X.; Söderling, E.; Liu, F.; He, J.; Lassila, L.V.J.; Vallittu, P.K. Optimizing the Concentration of Quaternary Ammonium Dimethacrylate Monomer in Bis-GMA/TEGDMA Dental Resin System for Antibacterial Activity and Mechanical Properties. J. Mater. Sci. Mate Med. 2014, 25, 1387–1393. [Google Scholar] [CrossRef] [PubMed]
- Huang, Q.T.; He, J.W.; Lin, Z.M.; Liu, F.; Lassila, L.V.J.; Vallittu, P.K. Physical and Chemical Properties of an Antimicrobial Bis-GMA Free Dental Resin with Quaternary Ammonium Dimethacrylate Monomer. J. Mech. Behav. Biomed. Mater. 2016, 56, 68–76. [Google Scholar] [CrossRef] [PubMed]
- Manouchehri, F.; Sadeghi, B.; Najafi, F.; Mosslemin, M.H.; Niakan, M. Synthesis and Characterization of Novel Polymerizable Bis-Quaternary Ammonium Dimethacrylate Monomers with Antibacterial Activity as an Efficient Adhesive System for Dental Restoration. Polym. Bull. 2019, 76, 1295–1315. [Google Scholar] [CrossRef]
- Liang, X.; Huang, Q.; Liu, F.; He, J.; Lin, Z. Synthesis of Novel Antibacterial Monomers (UDMQA) and Their Potential Application in Dental Resin. J. Appl. Polym. Sci. 2013, 129, 3373–3381. [Google Scholar] [CrossRef]
- Chrószcz, M.W.; Barszczewska-Rybarek, I.M. Synthesis and Characterization of Novel Quaternary Ammonium Urethane-Dimethacrylate Monomers—A Pilot Study. Int. J. Mol. Sci. 2021, 22, 8842. [Google Scholar] [CrossRef] [PubMed]
- Drejka, P.; Chrószcz-Porębska, M.; Kazek-Kęsik, A.; Chladek, G.; Barszczewska-Rybarek, I. Chemical Modification of Dental Dimethacrylate Copolymer with Tetramethylxylylene Diisocyanate-Based Quaternary Ammonium Urethane-Dimethacrylates—Physicochemical, Mechanical, and Antibacterial Properties. Materials 2024, 17, 298. [Google Scholar] [CrossRef] [PubMed]
- Zhang, L.; Ma, Z.; Wang, R.; Zuo, W.; Zhu, M. Bis-quaternary ammonium betulin-based dimethacrylate: Synthesis, characterization, and application in dental restorative resins. Mater. Adv. 2023, 4, 2127–2137. [Google Scholar] [CrossRef]
- Makvandi, P.; Ghaemy, M.; Mohseni, M. Synthesis and Characterization of Photo-Curable Bis-Quaternary Ammonium Dimethacrylate with Antimicrobial Activity for Dental Restoration Materials. Eur. Polym. J. 2016, 74, 81–90. [Google Scholar] [CrossRef]
- Ge, Y.; Wang, S.; Zhou, X.; Wang, H.; Xu, H.H.K.; Cheng, L. The Use of Quaternary Ammonium to Combat Dental Caries. Materials 2015, 8, 3532–3549. [Google Scholar] [CrossRef] [PubMed]
- Gilbert, P.; Moore, L.E. Cationic antiseptics: Diversity of action under a common epithet. J. Appl. Microbiol. 2005, 99, 703–715. [Google Scholar] [CrossRef]
- Yudovin-Farber, I.; Beyth, N.; Weiss, E.I.; Domb, A.J. Antibacterial Effect of Composite Resins Containing Quaternary Ammonium Polyethyleneimine Nanoparticles. J. Nanopart Res. 2010, 12, 591–603. [Google Scholar] [CrossRef]

| Signal Symbol | Hydrogen Atom | Multiplicity | Number of Protons | Chemical Shift [ppm] |
|---|---|---|---|---|
| a | CH3-C= | S | 6 | 1.95 |
| b | =CH2 | 2m | 4 | 5.70 and 6.14 |
| c | -O-CH2-CH2-N+- | m | 4 | 4.33–4.91 |
| d | -O-CH2-CH2-N+- | m | 4 | 4.00–4.26 |
| e | -N+-CH3 | s | 6 | 3.30–3.77 |
| f | -O-CH2-CH2-N+- | m | 4 | 4.00–4.26 |
| g | -O-CH2-CH2-N+- | m | 4 | 4.33–4.91 |
| h | -NH-C=O | m | 2 | 7.10–7.80 |
| i | -N+-CH2-CH2-(CH2)5(or 7 or 9)-CH3 1 | m | 4 | 3.30–3.77 |
| j | -N+-CH2-CH2-(CH2)5(or 7 or 9)-CH3 1 | m | 4 | 1.49–1.88 |
| k | -N+-CH2-CH2-(CH2)5(or 7 or 9)-CH3 1 | m | 20/28/36 2 | 1.16–1.47 |
| l | -N+-CH2-CH2-(CH2)5(or 7 or 9)-CH3 1 | m | 6 | 0.82–1.00 |
| m | CH3-C-CH3 | m | 12 | 1.49–1.88 |
| n | -CH- (Ar) | m | 1 | 7.10–7.80 |
| o | -CH- (Ar) | m | 2 | 7.10–7.80 |
| p | -CH- (Ar) | m | 1 | 7.10–7.80 |
| Signal Symbol | Carbon Atom | Chemical Shift [ppm] |
|---|---|---|
| a | CH3-C= | 21 |
| b | =CH2 | 130 |
| c | CH3-C=CH2 | 138 |
| d | -O-C=O | 169 |
| e–h | -CH2- | 59–67 |
| i | -N+-CH3 | 53 |
| j | -N+-CH2-(CH2)6(or 8 or 10)-CH3 1 | 59–67 |
| k | -N+-CH2-(CH2)6(or 8 or 10)-CH3 1 | 26–35 |
| l | -N+-CH2-(CH2)6(or 8 or 10)-CH3 1 | 17 |
| m | -NH-C=O | 157 |
| n | -NH-C- | 59–67 |
| o | >C-CH3 | 26–35 |
| p–s | -CH= (Ar) | 124–126 |
| t | >C= (Ar) |
| Sample | Staphylococcus aureus (logCFU/mL) | Escherichia coli (logCFU/mL) |
|---|---|---|
| Experimental copolymers | ||
| 20(QA8+TMXDI) | 4.97 ± 0.28 | 3.94 ± 0.97 |
| 20(QA10+TMXDI) | 6.41 ± 0.03 | 5.57 ± 0.73 |
| 20(QA12+TMXDI) | 6.32 ± 0.17 | 6.26 ± 0.23 |
| 40(QA8+TMXDI) | 2.39 ± 0.62 | Not observed |
| 40(QA10+TMXDI) | 5.41 ± 0.27 | 1.76 ± 0.67 |
| Reference copolymer | ||
| 40(UDMA) | 6.21 ± 0.21 | 6.26 ± 0.51 |
| Control | ||
| Sterile water | 11.42 ± 0.05 | 11.01 ± 0.25 |
Disclaimer/Publisher’s Note: The statements, opinions and data contained in all publications are solely those of the individual author(s) and contributor(s) and not of MDPI and/or the editor(s). MDPI and/or the editor(s) disclaim responsibility for any injury to people or property resulting from any ideas, methods, instructions or products referred to in the content. |
© 2024 by the authors. Licensee MDPI, Basel, Switzerland. This article is an open access article distributed under the terms and conditions of the Creative Commons Attribution (CC BY) license (https://creativecommons.org/licenses/by/4.0/).
Share and Cite
Drejka, P.; Chrószcz-Porębksa, M.; Kazek-Kęsik, A.; Barszczewska-Rybarek, I. Antibacterial Properties of Dental Copolymer Modified with Monomers Possessing Quaternary Ammonium Groups. Biol. Life Sci. Forum 2024, 35, 10. https://doi.org/10.3390/blsf2024035010
Drejka P, Chrószcz-Porębksa M, Kazek-Kęsik A, Barszczewska-Rybarek I. Antibacterial Properties of Dental Copolymer Modified with Monomers Possessing Quaternary Ammonium Groups. Biology and Life Sciences Forum. 2024; 35(1):10. https://doi.org/10.3390/blsf2024035010
Chicago/Turabian StyleDrejka, Patryk, Marta Chrószcz-Porębksa, Alicja Kazek-Kęsik, and Izabela Barszczewska-Rybarek. 2024. "Antibacterial Properties of Dental Copolymer Modified with Monomers Possessing Quaternary Ammonium Groups" Biology and Life Sciences Forum 35, no. 1: 10. https://doi.org/10.3390/blsf2024035010
APA StyleDrejka, P., Chrószcz-Porębksa, M., Kazek-Kęsik, A., & Barszczewska-Rybarek, I. (2024). Antibacterial Properties of Dental Copolymer Modified with Monomers Possessing Quaternary Ammonium Groups. Biology and Life Sciences Forum, 35(1), 10. https://doi.org/10.3390/blsf2024035010







